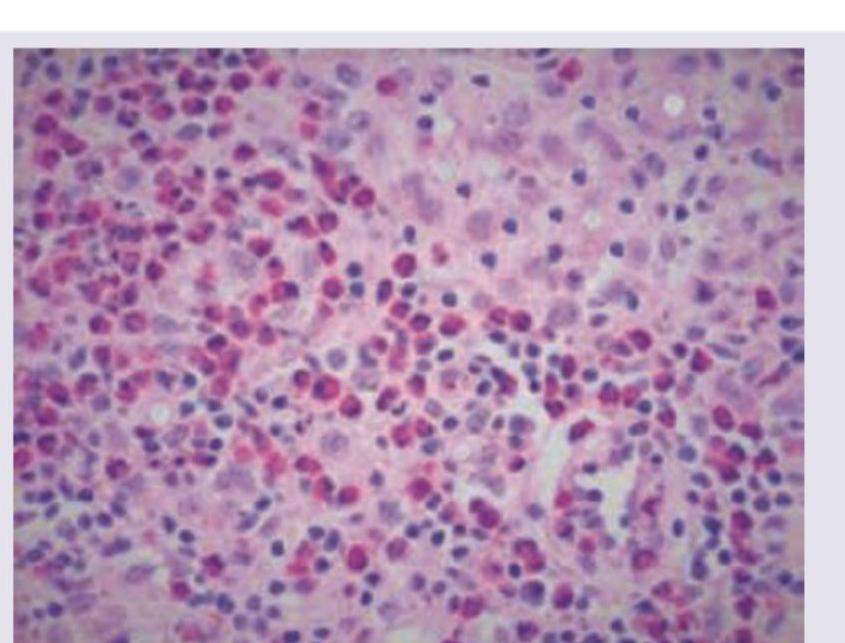
Image for question 368

Enter your email to get your 85% OFF code and unlock the full NEET PG question bank on the app.
Which of the following is NOT a characteristic feature of a granuloma?
Which of the following is not a proinflammatory cytokine?
A 95-year-old woman touches a pot of boiling water. Within 2 hours, she has marked erythema of the skin of the fingers of her hand, and small blisters appear on the finger pads. This has led to which one of the following inflammatory responses?
A 40-year-old man presents with a 5-day history of productive cough and fever. *Pseudomonas aeruginosa* is isolated from a pulmonary abscess. A complete blood count (CBC) shows a marked leukocytosis (50,000/mL) with a left shift in granulocytes. Which of the following terms best describes these hematologic findings?
Caspase-1 mediated cell death with inflammation is known as
The image shows presence of which cells?

The image shows a histological section of intestinal tissue with a granuloma. What is the most likely diagnosis?

A patient presents with a solitary bone lesion. Histopathological examination shows the following microscopic features. What is the most likely diagnosis?
The maximum tensile strength that a wound can reach after healing is complete, in comparison to normal skin, is
Langhans' giant cells are characteristically seen in
Acute Inflammation: Vascular Events
Practice Questions
Acute Inflammation: Cellular Events
Practice Questions
Chemical Mediators of Inflammation
Practice Questions
Chronic Inflammation
Practice Questions
Granulomatous Inflammation
Practice Questions
Systemic Effects of Inflammation
Practice Questions
Wound Healing
Practice Questions
Tissue Regeneration
Practice Questions
Fibrosis and Repair
Practice Questions
Resolution of Inflammation
Practice Questions
Get full access to all questions, explanations, and performance tracking.
Scan to download app